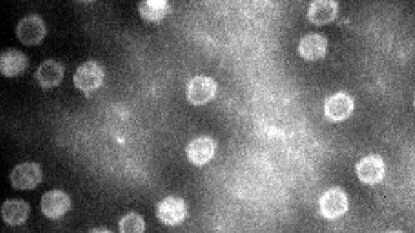

করোনার পর আবার এক ভাইরাসের দাপাদাপি! বাঁচতে হলে ভ্যাকসিনই একমাত্র ভরসা!
- Written by:Trending Desk
- local18
- Published by:Suman Majumder
Last Updated:
Parvo Virus: করোনার প্রভাব কাটিয়ে উঠতে না উঠতেই আবার নতুন ভাইরাসের দাপট।
কলকাতা: করোনা অতিমারীর প্রভাব কাটিয়ে উঠতে না উঠতেই আবার নতুন করে দেখা দিচ্ছে ভাইরাসের দাপট। এবার এই ভাইরাসে আক্রান্ত হওয়ার সম্ভাবনা রয়েছে প্রিয় পোষ্যটির।
তাই যদি দেখা যায় বাড়ির কুকুরটি কয়েকদিন ধরে অস্বাভাবিক কোনও আচরণ করছে, তবে সতর্ক থাকতে হবে। দেরি না করে তার শারীরিক পরীক্ষার জন্য পশুচিকিৎসা কেন্দ্রে নিয়ে যেতে হবে। কারণ, এমন হতেও পারে, প্রিয় পোষ্যটি হয়তো ভয়ঙ্কর পারভো ভাইরাসের শিকার।
আরও পড়ুন- সুপ্রিম রায়ে স্বস্তি শিন্ডে শিবিরে! একনাথ-বিজেপিকে কটাক্ষ উদ্ধবের
জানা গিয়েছে, সারা দেশেই সারমেয়দের মধ্যে ছড়িয়ে পড়ছে পারভো ভাইরাস। মধ্যপ্রদেশের রাজধানী ভোপালের পশুচিকিৎসকদের কাছে প্রতিদিন ৫-৬টি করে কুকুর নিয়ে আসা হচ্ছে শারীরিক অসুস্থতার কারণে। পরে জানা যাচ্ছে ওই কুকুরগুলি পারভো ভাইরাসে আক্রান্ত।
advertisement
advertisement
পারভো ভাইরাসের আক্রান্ত কুকুরের সময় মতো চিকিৎসা না করালে তারা রক্ত বমি করতে পারে। পরিস্থিতিত হাতের বাইরে চলে গেলে মৃত্যুও হতে পারে।
বিশেষজ্ঞরা বলছেন, আবহাওয়ার আকস্মিক পরিবর্তন এবং গরমের দ্রুত বৃদ্ধির কারণে বেশির ভাগ পোষা প্রাণী অসুস্থ হয়ে পড়ছে। আবহাওয়া পরিবর্তনের কারণে পোষা প্রাণীদের মধ্যে পারভো ভাইরাস খুব দ্রুত ছড়িয়ে পড়ছে। তবে এই ভাইরাস থেকে বাঁচার জন্য টিকা রয়েছে।
advertisement
পারভো ভাইরাসের আক্রমণের ধরন—
পারভো ভাইরাস অন্ত্রের ভিতরে কাজ করে। পাচনতন্ত্রে বাধা সৃষ্টি হয়। এই ভাইরাসের সংক্রমণ ঘটলে ডায়রিয়ার মতো উপসর্গ দেখা দিতে পারে। কুকুরের আচরণে হঠাৎ পরিবর্তন হয়।
এই ভাইরাসে আক্রান্ত হওয়ার পর কুকুরদের কাশি, হাঁচি, খাবার কম খাওয়া, জল না পান করা, নাক শুকিয়ে যাওয়ার মতো মতো সমস্যা দেখা দিতে পারে। রক্ত বমিও হতে পারে।
advertisement
টিকাই একমাত্র সমাধান—
পশুচিকিৎসক বিপিন পাল জানান, এই পারভো ভাইরাস থেকে কুকুরকে বাঁচাতে হলে তিনটি টিকা দিতে হয়। প্রথম টিকা দিতে হবে দেড় মাস বয়সে, দ্বিতীয়টি আড়াই মাস বয়সে এবং তৃতীয়টি তিন মাস বয়সে। প্রতিটি টিকার দাম প্রায় ২০০ টাকা। সরকারি পশু হাসপাতালেও এই টিকা পাওয়া যায়।
দেশের সব লেটেস্ট খবর ( National News in Bengali ) এবং বিদেশের সব খবর ( World News in Bengali ) পান নিউজ 18 বাংলায় ৷ দেখুন ব্রেকিং নিউজ এবং টপ হেডলাইন নিউজ 18 বাংলার লাইভ টিভিতে ৷ ডাউনলোড করুন নিউজ 18 বাংলার অ্যাপ অ্যান্ড্রয়েড এবং আইওএস-এ ৷ News18 Bangla-কে গুগলে ফলো করতে ক্লিক করুন এখানে ৷
Location :
Kolkata,West Bengal
First Published :
May 11, 2023 5:23 PM IST